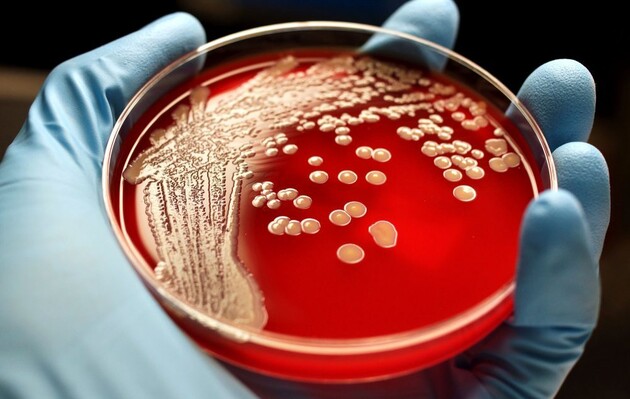
Одеський обласний лабораторний центр підтвердив випадок сибірської виразки.

В Одеській області підтвердили випадок сибірської виразки, передає Центр громадського здоров'я.
Пацієнт займається перепродажем тварин. Він звернувся до лікаря лише на п'ятий день після підвищення температури і появи на гомілці фурункула, який перейшов у виразку.
"Фахівці обласного лабораторного центру і Держпродспожівслужби вживають необхідних заходів щодо недопущення поширення захворювання. Організовано медичний нагляд за контактними особами, проведення повного комплексу протиепідемічних та профілактичних заходів в осередку", - йдеться в повідомленні.
Зараження сибірською виразкою відбувається:
- через пошкоджену шкіру або слизові оболонки при догляді за хворими тваринами;
- під час обробки туш, зняття шкіри і поховання останків загиблих тварин;
- при контакті з різними видами сировини, отриманої від хворих тварин;
- при вживанні в їжу м'яса хворих тварин;
- через укуси комах;
- не виключається зараження через ґрунт або предмети, забруднені збудником.
Сибірська виразка не поширена в Україні. Але масові спалахи медики припускають.
Нагадаємо, що вірус натуральної віспи знайшли в останках вікінгів. Ймовірно, стародавні вікінги розповсюдили вірус Європою. Його виявили в зубах древніх вікінгів і дослідники вважають, що саме вони могли поширити вірус.